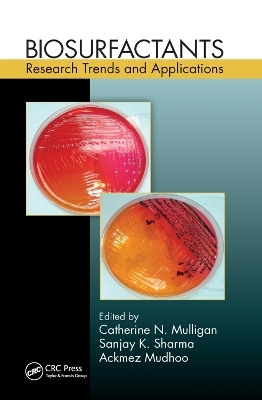
Biosurfactants -

Biosurfactants
CRC Press (Verlag)
978-0-367-37889-9 (ISBN)
This book reviews current knowledge and the latest advances, strategies for improving production processes, and the status of biosynthetic and genetic regulation mechanisms for microbial surfactants. Chapters present research findings on specific biosurfactants, such as high surface activity rhamnolipids, yeast-derived sophorolipids, lipopeptides, and trehalose lipids that have potential for environmental, industrial, and medical uses. The book also describes sources and characteristics of marine microbial biosurfactants, biosurfactants made from food processing by-products and biosurfactants used in the food industry, and biosurfactants for green synthesis of nanoparticles.
The text presents applications of biosurfactants in environmental industries and examines interactions between metals and various classes of biosurfactants and related metal remediation technologies. The final chapter reviews the state of the art of biosurfactants and their applications, and proposes approaches to overcome any challenges.
Professor Catherine N. Mulligan, Ph.D., holds a Concordia Research Chair in Geoenvironmental Sustainability (Tier I) and is a full professor and associate dean, research and graduate studies, of the Faculty of Engineering and Computer Science. She has more than 25 years of research experience in government, industrial, and academic environments. She has authored over 80 refereed papers in various journals, holds 3 patents, and has supervised to completion more than 40 graduate students. Professor Mulligan serves as the director of the Concordia Institute of Water, Energy and Sustainable Systems, which trains students in sustainable development practices and promotes research into new systems, technologies, and solutions for water, energy, and resource conservation. An internationally acclaimed, Fellow of Royal Society of Chemistry (UK) Prof. Sanjay K. Sharma, FRSC is a Ph.D. (1999) in Organic Chemistry from Rajasthan University, Jaipur, India and is a renowned author and editor of many books, research journals, and hundreds of articles from last twenty years. He has authored over 100 Research papers including many comprehensive Review articles in high-impact journals of international repute and contributed 21 Books from the internationally acclaimed publication houses so far. For his contribution in the area of Green Chemistry and Environmental Sustainability, he has also been included in the "World Ranking of Top 2% Scientists" for last two consecutive years (i.e. 2020 and 2021) published by Stanford University, USA. Presently Prof. Sharma is working as Professor of Chemistry and Dean (Research) at JECRC University, Jaipur, India. Ackmez Mudhoo currently serves as a lecturer in the Department of Chemical and Environmental Engineering at the University of Mauritius and is pursuing his Ph.D. in chemical engineering under the supervision of Professor Romeela Mohee (Pro-Vice Chancellor - Academia) and Associate Professor Dr. Bhola R. Gurjar (Department of Civil Engineering, Indian Institute of Technology, Roorkee). His re
Green chemistry and Biosurfactant Research. Amphiphilic Molecules of Microbial Origin. Rhamnolipids. Sophorolipids. Biosurfactants and Bioemulsifiers from Marine Sources. Characterization, Production, and Applications of Lipopeptides. Biosurfactants in the Food Industry. Trehalose Biosurfactants. Biosurfactant-Mediated Nanoparticle Synthesis. Enhancement of Remediation Technologies with Biosurfactants. Biosurfactant Complexation of Metals and Applications for Remediation. Biosurfactants. Index.
| Erscheinungsdatum | 30.09.2019 |
|---|---|
| Verlagsort | London |
| Sprache | englisch |
| Maße | 156 x 234 mm |
| Gewicht | 453 g |
| Themenwelt | Naturwissenschaften ► Chemie ► Physikalische Chemie |
| Naturwissenschaften ► Chemie ► Technische Chemie | |
| Technik | |
| ISBN-10 | 0-367-37889-2 / 0367378892 |
| ISBN-13 | 978-0-367-37889-9 / 9780367378899 |
| Zustand | Neuware |
| Informationen gemäß Produktsicherheitsverordnung (GPSR) | |
| Haben Sie eine Frage zum Produkt? |
aus dem Bereich


